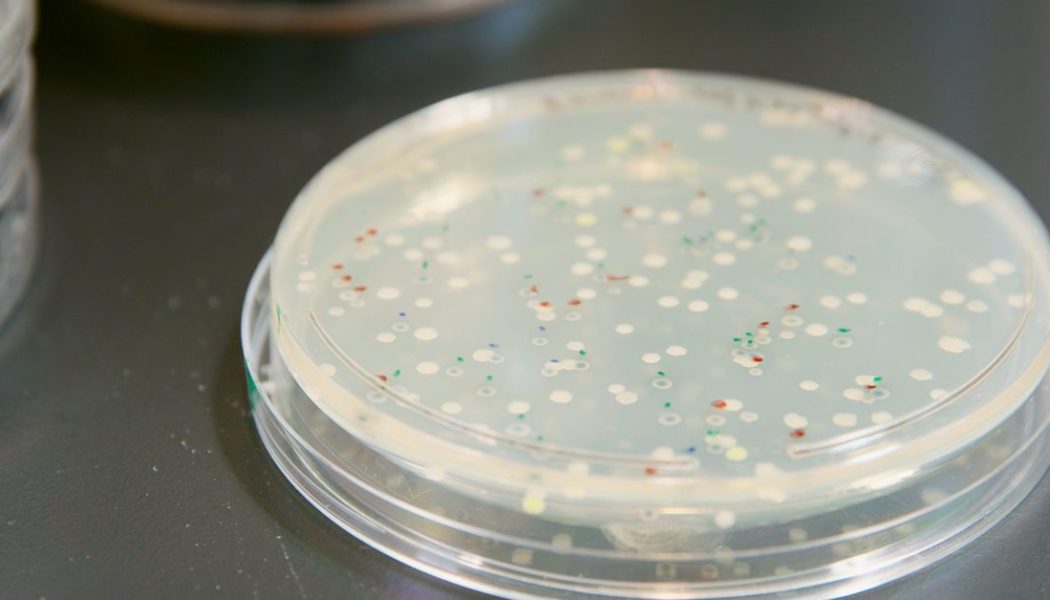
How microbes could help dye your next pair of blue jeans

Blue jeans are an iconic staple of just about any wardrobe. But all that denim has a dirty secret: the dye that makes blue jeans so ubiquitous is actually made from fossil fuels and toxic chemicals. For thousands of years, when humans wanted to get a deep blue color, they used natural indigo from Indigofera plants. But in 1897, German chemists started selling a cheaper synthetic version for industrial use. Most pairs of jeans today are dyed with synthetic indigo.
It’s hard to say just how many jeans are made each year, but most estimates are in the billions. To get that blue color, over 70,000 tons of indigo dye are made each year. When the dye (and garment dyes in general) isn’t handled properly, it can end up polluting waterways, damaging local ecosystems, and impacting public health. Luckily, an alternative to synthetic indigo could eventually clean up this step of the manufacturing process.
Huue is a startup in Berkeley, California, on a mission to reverse engineer indigo molecules using microbes and sugar. They’re still in the R&D phase, testing out different strains and inputs to achieve a product that could drop into existing production processes. The next challenge is implementing their creation at scale and even expanding to other dyes. We spent a day in their lab to see how it all worked and even did some tie-dyeing on our own. Check out our video to see a colorful solution to a dirty process.